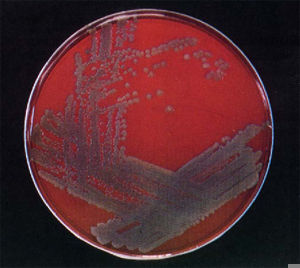
金葡菌

藥品介紹
黃連素在臨床中一直作為非處方藥用於治療腹瀉,但是現代藥理學研究證實黃連素具有顯著的抗心力衰竭、抗心律失常、降低膽固醇、抗制血管平滑肌增殖、改善胰島素抵抗、抗血小板、抗炎等作用,因而在心血管系統和神經系統疾病方面將可能有廣泛、重要的套用前景,日益受到重視。
用中醫學解釋,此類藥物性涼,能清除邪熱或虛熱,清除有害毒物,自古以來就是中醫手中的一味清熱解毒良藥。通常每次口服0.1~0.5克,每日三次。勿越界使用
是眾多治療腹瀉藥物中最為大家熟知、價格便宜、服用簡單、攜帶方便的藥物之一。所以,幾乎家家戶戶備有此藥,無論出差還是旅遊,黃連素更是人們的必備藥物之一。許多人在腹瀉時第一時間就會想起它。應當說,它是一種物美價廉的好藥。不過,要用好它,還是有許多訣竅的。在兩年多前,國家藥監局曾公布了一批停用的藥品,其中包括複方黃連素片和複方黃連素注射液,有媒體誤報黃連素已停用,引起了很大的誤會。所謂的“複方黃連素”,是按照地方標準生產的藥物,此次停用是因為“質量不可控”,該藥與我們常說的黃連素是完全不同的藥物。黃連素仍收錄於國家基本藥品目錄,使用非常安全。
 血小板
血小板其次,腹瀉的原因很多,總體可分感染性腹瀉,多呈急性腹瀉;非感染性腹瀉,多呈慢性腹瀉。由上面對黃連素藥理作用的介紹可知,黃連素只適用於感染性腹瀉。胃腸感染表現可輕可重,輕者僅腹痛、腹瀉,重者會有噁心、嘔吐、發熱寒戰、食欲不振,嚴重時導致脫水、酸中毒、休克。一般而言,對輕型炎症可以選用黃連素,對於重型則必須合用抗感染作用強的抗生素。
而慢性非感染性腹瀉的病因複雜,腸易激綜合徵、潰瘍性結腸炎、營養不良、內分泌疾病、肝硬化、尿毒症、過敏性疾病、癌症等,都可以導致慢性腹瀉。對非感染性的腹瀉、腹痛,黃連素是毫無作用的。像常見的過敏性蕁麻疹胃腸型,如果不採取解除過敏綜合治療,僅用黃連素是控制不了腹瀉的。而腸易激綜合徵的患者,在吃2~3片黃連素後,腹痛、腹瀉常常會消失,但這並非黃連素的功勞。因為腸易激綜合徵是可自行緩解的疾病,但又是反覆發病難以根治的病症,其腹瀉症狀的消失,與吃黃連素無關。
 消化道
消化道黃連素口服後,只停留在腸道內不被吸收,故不良反應很小。有科學家曾給小鼠按每千克體重8克的用量服用黃連素,24小時後尚有半數存活。如果換作60千克的人,相當於每天吃上接近250克黃連素。當然,“是藥三分毒”,口服黃連素後也可能會產生噁心、嘔吐、和藥物熱等不良反應。而且,由於黃連素具有一定的固澀止瀉作用,有的人在服用黃連素之後腹瀉可能是止住了,但繼之又發生了便秘。另外,經常服用黃連素易產生耐藥性,不僅不能消除腹瀉、腹痛,甚至還會加劇腹瀉、腹痛,以及其他一些想避免卻又忽視了的不良反應。
作用
一、抗病原微生物作用1、抗菌作用;
2、抗病毒作用;
3、抗原蟲;
4、抗毒作用。
金葡菌
金葡菌1、抗心律失常;
2、降低血壓;
3、正性肌力;
4、臨床報導黃連素對缺血性腦損傷有保護作用。
三、降血糖作用大量的藥理及臨床研究證實,小檗鹼不僅有顯著的降血糖作用,而且對糖尿病人伴有的合併症高血壓血栓形成等有良好的防治作用。
四、抗炎作用。五、抑制血小板聚集作用。
六、增強免疫功能。
七、抗癌。
八、其他作用。
1、抗潰瘍作用;
2、解熱作用;
3、黃連還具有中樞抑制和利膽等作用。
鑑別
取本品的細粉適量(約相當於鹽酸小檗鹼0.1g),加水10ml,緩緩加熱使鹽酸小檗鹼溶解,濾過,取濾液,照鹽酸小檗鹼項下的鑑別試驗,顯相同的反應。檢查
溶出度取本品,照溶出度測定法,以水1000ml為溶劑,轉速為每分鐘120轉,依法操作,經45分鐘時,取溶液5ml,濾過,取續濾液2ml置25ml量瓶中,加水稀釋至刻度,搖勻,照分光光度法,在263nm的波長處測定吸收度,按C20H18ClNO4.2H2O的吸收係數(E1%1cm)為724計算出每片的溶出量。限度為標示量的70%,應符合規定。其他應符合片劑項下有關的各項規定。含量測定
取本品20片,如為糖衣片,注意除去糖衣,精密稱定,研細,精密稱取適量(約相當於鹽酸小檗鹼0.3g),置燒杯中,加沸水150ml,攪拌使鹽酸小檗鹼溶解,放冷,移入25ml量瓶中,照鹽酸小檗鹼項下的方法,自“精密加重鉻酸鉀滴定液(0.01667mol/L)50ml,加水至刻度”起,依法測定。每1ml重鉻酸鉀滴定液(0.01667mol/L)相當於13.60mg的C20H18ClNO4.2H2O。藥理作用
本品含鹽酸小檗鹼(C20H18ClNO4.2H2O)應為標示量的93.0%~107.0%。本品對細菌只有微弱的抑菌作用,但對痢疾桿菌、大腸桿菌引起的腸道感染有效。 本品為毛莨科植物黃連根莖中所含的一種主要生物鹼,可由黃連、黃柏或三棵針中提取,也可人工合成。藥理毒理
1.含鞣質的中藥與黃連素合用後,由於鞣質是生物鹼沉澱劑,二者結合,生成難溶性鞣酸鹽沉澱,降低療效。
2.如正在服用其他藥品,使用本品前請諮詢醫師或藥師。
【類別】同鹽酸小檗鹼。
【規格】(1)0.025g(2)0.05g(3)0.1g
【貯藏】遮光,密封保存。
【性狀】本品為淡黃色糖衣片,除去糖衣後顯黃色。
【作用類別】本品為止瀉藥類非處方藥藥品
【不良反應】口服不良反應較少,偶有噁心、嘔吐、皮疹和藥熱,停藥後消失。
【作用類別】本品為止瀉藥類非處方藥藥品。
【適應症】用於腸道感染,如胃腸炎。
【性狀】本品為黃色片或糖衣片。
藥理毒理注意
1、對本品過敏者、溶血性貧血患者禁用。
遺傳6-磷酸葡萄糖脫氫酶缺乏的兒童應禁用,因本品可引起溶血性貧血以致黃疸。
2、妊娠期頭三個月慎用。
3、如服用過量過出現嚴重不良反應,請立即就醫。
4、當藥品性狀發生改變時禁止使用。
5、兒童必須在成人監護下使用。
6、請將此藥品放在兒童不能接觸的地方。
7、黃連素與茶不可同吃。服用黃連素前後2小時內應禁止飲茶。茶水中含有約10%的鞣質,鞣質是生物鹼沉澱劑,可與黃連素中的生物鹼結合形成難溶性的鞣酸鹽沉澱,降低黃連素的藥效。
用法用量
口服,成人:一次1-3片,一日3次;兒童用量見說明書。
禁忌溶血性貧血患者及葡萄糖-6-磷酸脫氫酶缺乏患者禁用。
其他相關
降血脂研究
 DNA
DNA在國家自然科學基金委員會的大力支持下,由中國醫學科學院醫藥生物技術研究所所長蔣建東博士領導的課題組經過多年攻關,從基因序列、細胞、動物實驗以及臨床治療等多個層面和角度,對小檗鹼降低血中膽固醇和甘油三酯的藥理作用、藥效和分子機理進行了系統研究。他們發現,小檗鹼是在基因轉錄後水平上,通過作用於3'UTR區域穩定低密度脂蛋白受體的mRNA(信使核糖核酸)來降低血脂的,與使用的他汀類降血脂藥物的作用機理完全不同。這在理論上為尋找新型降血脂藥物提供了新的分子靶點。臨床研究表明,口服小檗鹼(三個月每日1克)可以使高血脂病人的膽固醇、低密度脂蛋白和甘油三酯下降20%~35%,這一結果進一步被高血脂金色倉鼠模型動物實驗所證實。課題組骨幹、南京市第一醫院魏靜醫師和來自美國加州帕拉爾托榮軍醫院的華裔科學家劉敬文博士均表示,小檗鹼可能成為他汀類藥物的替代藥,並有望用於與他汀類藥物聯合治療心血管疾病。
調節血脂
天然藥物成分小檗鹼不僅可用於細菌性痢疾的治療,而且被發現具有調節血脂的作用。這項由中國醫學科學院醫藥生物技術研究所領導的綜合研究項目“小檗鹼治療高膽固醇血症的基礎、臨床研究及類似物或前藥的開發”不久前獲得第七屆“德彪-CCRF中國獎”一等獎。植物藥物黃連的有效化學單體成分小檗鹼在我國套用於臨床已有很長時間,主要作為非處方藥物治療細菌性痢疾。該所研究組及參加單位在工作中發現:小檗鹼在體外能顯著上調肝細胞低密度脂蛋白受體(LDLR)的表達。進一步的研究顯示,小檗鹼的作用是在轉錄後水平,通過激活細胞的胞外信號調節激酶來發揮作用,與臨床常用的他汀類降膽固醇藥物機理完全不同。臨床套用表明,小檗鹼用於治療高血脂患者療效良好,還適用於肝功能障礙的病人,安全性好,無他汀類藥物的不良反應。這項研究結果發表後被歐美多個研究單位和醫院證實,並受到國內外病人的接受和好評,使小檗鹼成為很有前景的降血脂藥物。
項目組的專家表示,這一藥物新作用的再發現,為中國傳統藥物小檗鹼賦予了全新的意義和價值。小檗鹼的工作正在深入進行中,並進一步注重新改造的最佳化物,探索在該領域理論與套用上的突破。
調節腸道菌群
上海交通大學教授趙立平選擇了一名體重175公斤、26歲的男性大胖子,試圖從他身上探索肥胖的致病菌。“醫學上一般認為,對於這么胖的人,營養干預和運動干預都是無效的,唯一的辦法是做胃腸的繞道手術。如果我們能夠通過改變飲食來調整腸道菌群,使他瘦下來,那就說明我們的理論立得住。”趙立平說。在進行營養干預前,這名肥胖者腸道內最優勢的菌群是陰溝腸桿菌,但干預4周后這種細菌就幾乎檢測不到了。在9周減重30公斤後,患者的身體狀況從“三高”等嚴重的代謝紊亂狀態逐步恢復正常。整個實驗結束時,他總共減了51.4公斤的重量。
趙立平懷疑陰溝腸桿菌可能是引發患者炎症和代謝紊亂的元兇,便將經過處理的該菌接種到無菌鼠體內,同時餵以高脂飼料。結果,小鼠嚴重地發胖,其肥胖程度與對照組——吃同樣飼料的正常有菌小鼠是一樣的,而且還出現了糖尿病的特徵——胰島素抵抗。由於戈登等人已經證明無菌小鼠吃高脂飼料不會肥胖,因而可以推論,陰溝腸桿菌是第一個被發現可導致肥胖與代謝紊亂的腸道細菌。
趙立平對黃連素的研究,則更加直接地證明了中藥的作用原理。黃連素又叫小檗鹼,是中藥黃連的主要有效成分,它本是一種治療細菌性腹瀉的非處方藥。國內有不少醫生將其用於糖尿病的治療,取得了很好的療效。然而,醫學界始終沒有搞清楚這一作用的機理。
在對小檗鹼的體外研究中,它的使用濃度都在毫克級,但大量研究表明,小檗鹼的生物利用度很低,口服後很難入血,基本都以原藥的形式從糞便排出體外,其在人體血液內的濃度只能達到微克級。一個藥物如果不能入血是不能發揮作用的,因而,小檗鹼對糖尿病的作用機理就像一團迷霧。
2004年以來,有很多研究顯示,結構失調的腸道菌群可能會造成內毒素入血,誘發慢性炎症,造成肥胖、糖尿病、冠心病等代謝性疾病。於是,趙立平猜想,小檗鹼在穿過腸道時,可能會改善腸道菌群的結構,減少內毒素入血,減輕慢性炎症,從而達到治療或預防糖尿病的目的。
於是,他們以大鼠作為模型,用高脂飼料誘導肥胖和胰島素抵抗等代謝紊亂,在飼餵高脂飼料的同時,灌服一定劑量的小檗鹼。結果令人稱奇:小檗鹼有效防止了肥胖和胰島素抵抗。根據這一結果,可以通俗地說,如果你在吃垃圾食品時,吃一些黃連素,就可能起到防止長胖的作用。
趙立平採用高通量測序技術測定動物的腸道菌群,結果顯示,小檗鹼非常顯著地改變了腸道菌群結構。2012年8月,這一研究結果發表在《公共科學圖書館·綜合》雜誌上,解釋了對小檗鹼預防代謝綜合徵的機理。
副作用
小檗鹼是黃連素的主要藥理成分之一,黃連素的學名就叫做“鹽酸小檗鹼”,是從黃連、黃檗中提煉出來的一種生物鹼。黃連素是治療細菌性胃腸炎、痢疾等消化道疾病的常用藥。黃連素的副作用比較小,但不等於說黃連素沒有副作用,醫學專家指出,醫學研究及臨床實踐發現,黃連素的主要副作用是可使胃酸過多,即中醫所說“苦敗胃”。同時,黃連素最常見的副作用是便秘,大量套用後偶有噁心、嘔吐、皮疹及發熱,甚至可能導致橫紋肌溶解症及乳酸中毒症。最需要警惕的是,常服黃連素可能會導致B族維生素吸收障礙,從而出現周圍神經炎。從研究進展來看,尚未闡明小檗鹼是如何影響營養代謝的,趙立平的團隊也正在努力探尋答案。其實,就像我們可以通過吃雞蛋可以補充蛋白質,但為了補充蛋白質而吃過多雞蛋的話,也會產生膽固醇過高等負面影響。因此,黃連素中的小檗鹼可能具有減肥的功效,但這絕不代表把黃連素當做減肥藥。愛美之心可以理解,但是為了健康減肥更需要理性。

